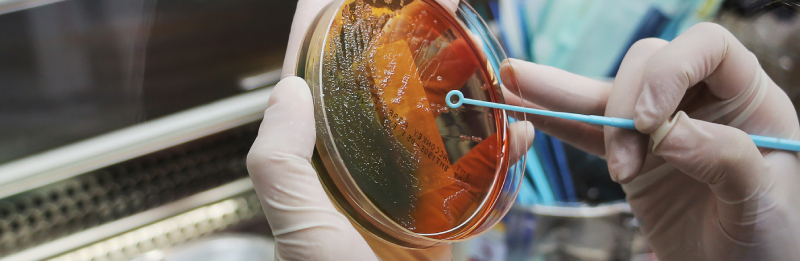

Microbiology & Serology
Microbiology is the branch of medical science that studies microorganisms such as bacteria, viruses, fungi, and parasites that can cause infections.
Serology involves the detection and measurement of antibodies and antigens in the blood to diagnose infectious diseases and monitor immune responses.
Microbiology and Serology together play a crucial role in infection diagnosis, prevention, treatment, and monitoring of disease outbreaks. They guide doctors in selecting appropriate antibiotics, antiviral or antifungal therapy, and help in evaluating immunity status.
Common Tests in Microbiology & Serology
Microbiology Tests
- Bacterial Culture & Sensitivity: Identifies bacterial infections and determines effective antibiotics.
- Urine, Blood, Stool Culture: Detects urinary, systemic, or gastrointestinal infections.
- Sputum & Throat Swab Tests: Diagnoses respiratory infections.
- Fungal Culture & Staining: Detects fungal infections.
- Parasitology Tests: Detects parasites in blood or stool.
Serology Tests
- HIV, Hepatitis B & C: Detection of viral infections through antibodies or antigens.
- Dengue, Malaria, Typhoid: Rapid tests and ELISA to detect specific infections.
- Autoimmune Screening: ANA, rheumatoid factor, and other immune-related disorders.
- Viral Load & Antibody Titers: Quantitative measurement for monitoring infections and immunity.
